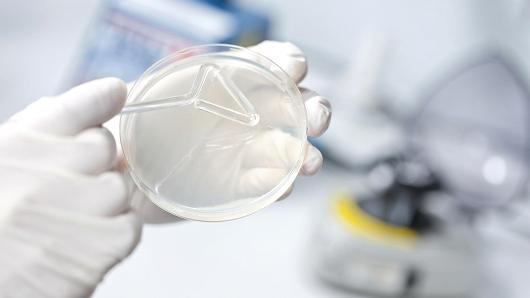

Kalyeena Makortoff
Journalist
London
Journalist
The Guardian

Kalyeena Makortoff is a Canadian-born journalist who traded the mountains of British Columbia for the bricked history of London back in 2012.
Now the Guardian's Banking Correspondent, she previously worked at the Press Association wire service where she started in a business reporter role and worked her way up to Chief City Correspondent.
That was after working for the London bureau of business broadcaster CNBC, where she gained experience as a live blogger, online reporter and junior TV producer.
Kalyeena graduated from the University of British Columbia with an BA in Political Science, but spent most of her university career writing for The Ubyssey and Grand Forks Gazette.